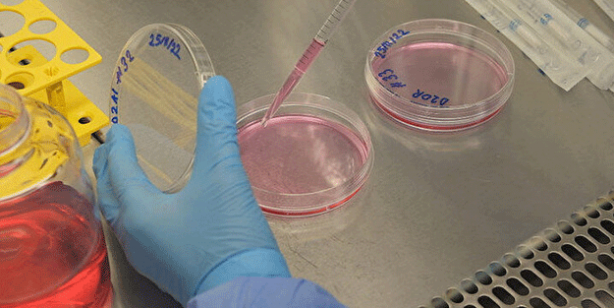
Türkiye'den kanserle ilgili 'devrimsel' buluş
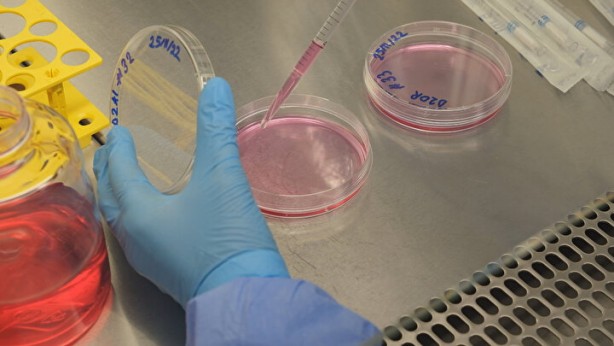
Foto - Türkiye'den kanserle ilgili 'devrimsel' buluş

Türkiye'den kanserle ilgili 'devrimsel' buluş
Araştırmacılar tarafından gerçekleştirilen çalışma ile birlikte dünyada ilk kez kanser hücrelerinin, CT-1 adlı bir molekül üzerinden çevre dokulara sinyal gönderdiği ve sağlıklı hücreleri 'kendi hizmetine alarak' yayılabildiği gösterildi. Çalışmayı gerçekleştiren ekibin başındaki Prof. Dr. Devrim Gözüaçık, bu keşif sayesinde ileride bazı kanser türlerinde hastalığın nasıl seyredeceği ile ilgili tanı aşamasındayken dahi önemli ipuçları elde etmenin mümkün olabileceğini belirtti. Gözüaçık, böylece yeni ilaçlar geliştirilebileceğini, kanserin ilerlemesinin ve yayılımın önlenebileceğini söyledi.